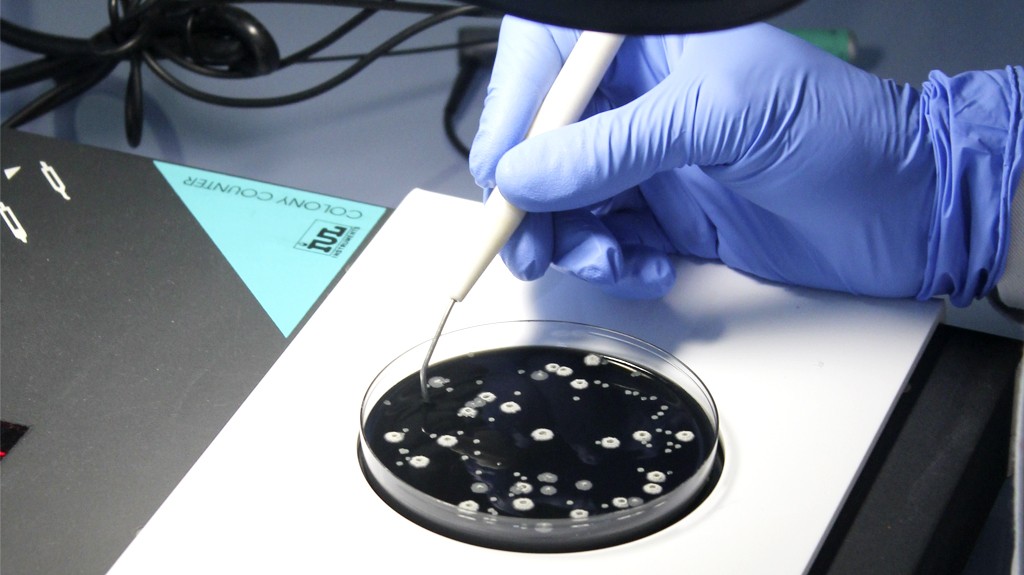
Ensayo Laboratorios

Gracias a Inteman, disponemos de un laboratorio de ensayos propio donde podemos ofrecer un servicio de análisis y estudios de primer nivel para todos nuestros clientes.
El equipo de profesionales de Tequil está formado por químicos y biólogos con amplia experiencia en hidrocarburos.
Disponemos de modernos equipamientos de laboratorio y equipo humano con alta formación y especialización. En Tequil hemos apostado por la biotecnología, dotando a nuestras instalaciones de los recursos técnicos necesarios y afianzando alianzas con universidades e instituciones públicas para lanzar planes de investigación conjuntos.
Gracias a nuestros clientes seguimos invirtiendo en I+d+i y apoyando la investigación para seguir desarrollando nuevas técnicas de ensayo y nuevos aditivos adecuados a los hidrocarburos legislados por el RD 1088/2010.